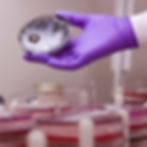
nettoyage carrelage sale - jointsnet 3.jpg

jointsnet.fr
Ce que vous ne voyez pas sous vos pieds peut nuire à votre santé

L’hygiène invisible des joints
Même si votre carrelage semble propre, les joints eux, retiennent l’humidité, la graisse, les résidus de savon ou de nourriture.
Avec le temps, ils deviennent un terrain idéal pour les bactéries, les moisissures et les germes invisibles.
On les oublie souvent… jusqu’à ce qu’un problème d’odeur, de tâche ou d’allergie apparaisse.
sur Montpellier et alentours

Bébé rampe, vous marchez pieds nus…
Votre bébé rampe au sol. Vos enfants jouent sur le carrelage. Vous marchez pieds nus dans la salle de bain.
Et pourtant, les joints peuvent héberger des bactéries qu’on ne voit pas, mais qui impactent la qualité de vie.
Un nettoyage classique ne suffit pas à les désincruster.
Ce que révèle la science les bactéries et moisissures présentes dans les joints
-
Jusqu’à 100 000 bactéries par m² dans des joints mal entretenus
-
La chaleur et l’humidité accélèrent la prolifération des moisissures invisibles
-
La vapeur sèche à 5 bars permet une désinfection naturelle et efficace, sans produit chimique


Pourquoi notre méthode change tout ?
Notre vapeur sèche à haute pression agit en profondeur dans les joints :
elle élimine les germes, désinfecte les pores et laisse vos sols immédiatement sains et utilisables.
Sans odeur, sans rinçage, sans produit toxique.



Vous ne voyez pas ce qu’il y a dans vos joints ? Nous, oui.
Et nous savons comment l’éliminer proprement.
Nettoyage sans dégradation du joint ou du revêtement
Aucun produit chimique ni rejet polluant
Sols immédiatement praticables
Intervention rapide à Montpellier et alentours
